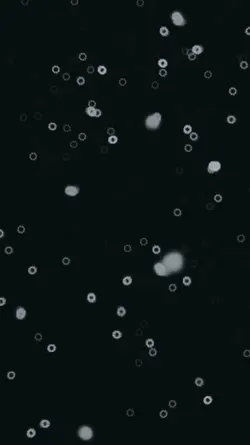
Double exposure

Free Double Exposure Final Cut Pro Templates By CapCut
Discover how to create breathtaking double exposure effects in Final Cut Pro with simple, step-by-step techniques. Enhance your videos by blending images and footage seamlessly, perfect for creative professionals and enthusiasts alike. Learn essential tips, recommended plugins, and workflows that will help you boost your editing skills and transform ordinary projects into visually captivating masterpieces. Explore easy ways to achieve cinematic double exposure looks, optimize your video editing process, and unlock the full potential of Final Cut Pro for unique creative results.
More Templates
458.1K
Rain Photoshoot

233.9K
Rain Photoshoot

201.7K
Ai Trenf Autofill

147.7K
amando intensamente

139.9K
Couple template

70.7K
Home Screen

33.4K
Double exposure

22.5K
Zoom Fill Out 0,2
22.3K
Double exposure

18.6K
Trend Transparente

11.7K
Merge Template

7.4K
Double exposure

7.1K
Double exposure

4.5K
Girl Tattoos

4.3K
New Double exposure

2.8K
Double Vision

2.7K
TRIPLE EXPOSURE

2.3K
Lily's capcut

644
Tunnel Effec

62
Self aware
1
Hot Templates
Template By CbpngFilter TemplateBlack TemplateBlur Video TemplateNew Template 2026 ProTentana MontageTemplates For PhotosPhoto TemplatesLoading TemplateFree TemplatesCute TemplatesZoom Animation EffectsText Effects TemplatesTemplate AestheticNew Template 2026 Sad8K Video Editing 2026New Templates 2026Name Title Template1 Minute Video Template30 Seconds Video TemplateTemplates 2026Video 2026OrbitArabic TemplateUnknown Montage30 Second Video Template4K Video Editing 20263D Special Effects1 Clip Video TemplateGolden BrownPhoto Edit Trending 2026Aa23 Template5 Clips Video Template3 Clips TemplateSubtitle Template3 Photo TemplateDownload Free TransitionsFree Sound Effects DownloadFestival TemplateBubble TemplatesTemplate Websites3 Photos TemplateBackground Blur Video Template25 Seconds Video Template24 Second Video TemplateHoli Video4K Video Editing 2026 TeluguRipple Effect AnimationPhoto Editing TemplateText Template
About double exposure final cut pro
Discover how to create breathtaking double exposure effects in Final Cut Pro with simple, step-by-step techniques. Enhance your videos by blending images and footage seamlessly, perfect for creative professionals and enthusiasts alike. Learn essential tips, recommended plugins, and workflows that will help you boost your editing skills and transform ordinary projects into visually captivating masterpieces. Explore easy ways to achieve cinematic double exposure looks, optimize your video editing process, and unlock the full potential of Final Cut Pro for unique creative results.


